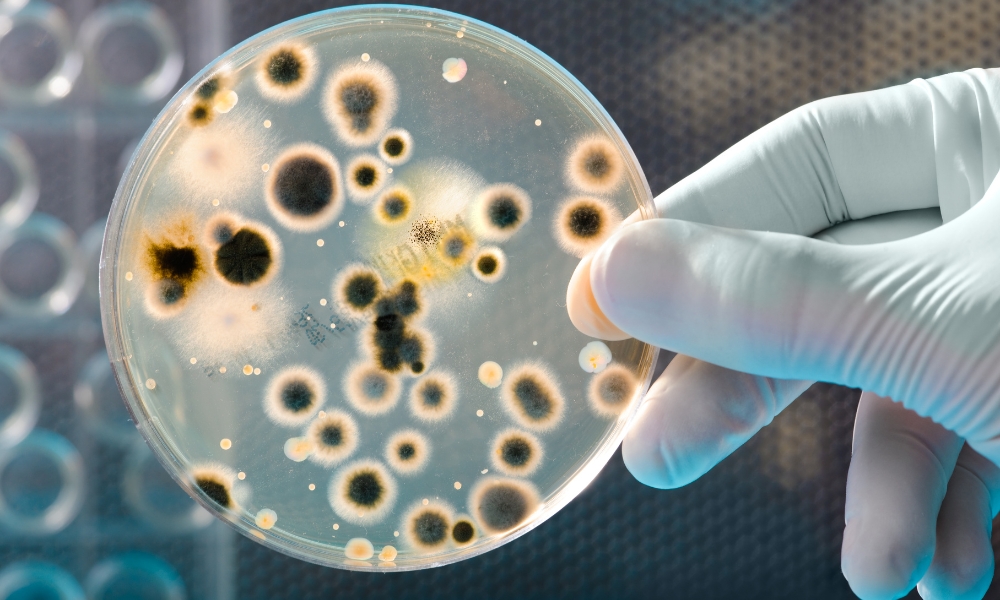
Šta znači kada veš "ne diše" i kako to utiče na vaše zdravlje 3 Razvoj gljivica i bakterija

Da li ste se ikada zapitali zašto vam je koža nadražena nakon nošenja omiljene majice? Ili zašto tek oprana odeća, iako naizgled čista, brzo poprimi neprijatan miris čim je obučete?
Problem se najčešće krije u fenomenu koji se naziva „veš koji ne diše“. Ovo se dešava kada vlakna vaše odeće izgube sposobnost efikasne apsorpcije i oslobađanja vlage i znoja.
Umesto toga, vlakna se zagušuju, stvarajući idealno okruženje za zadržavanje: znoja, ulja sa tela, bakterija i hemijskih ostataka deterdženata i, posebno, omekšivača.
Direktna veza između veša koji ne diše i vašeg zdravlja je jasna: ono što je loše za vlakna vaše odeće, loše je i za vašu kožu i disajne puteve.
U ovom tekstu naučićete kako da prepoznate problem, koji su glavni uzroci i kako da rešite problem „zagušenog“ veša, a da pritom zaštitite svoje zdravlje.

Tabela sadržaja
TogglePrepoznajte znakove da vaš veš „ne diše“
| Simptom na Vešu | Simptom na Koži/Zdravlju | Glavni Uzrok |
|---|---|---|
| Neprijatan miris odmah nakon pranja | Osip, svrab, iritacija kože od odeće | Zadržane bakterije i ostaci deterdženta/omekšivača |
| Odeća se čini kruta ili lepljiva | Pogoršanje ekcema ili dermatitisa | Prekomerno doziranje omekšivača i deterdženta |
| Peškiri slabo upijaju vodu | Gljivične infekcije, akne na telu (leđa) | Voštani sloj omekšivača oko vlakana |
| Sportski veš brzo „usmrdi“ | Crvenilo, kontaktni dermatitis | Sintetički materijali koji zarobljavaju znoj i ulja |
Glavni problem: zdravstvene posledice
Kada veš ne diše, on postaje generator problema, a vaša koža, kao najveći organ, trpi direktne posledice.
Kožne reakcije: iritacija i alergije

Hemijski ostaci zarobljeni u zagušenim vlaknima, u kombinaciji sa toplotom i vlagom, predstavljaju tempiranu bombu.
Najčešća posledica je kontaktni dermatitis, koji se manifestuje kao osip, crvenilo ili svrab.
Iritaciju kože od odeće najčešće izazivaju agresivni sintetički mirisi i konzervansi koji ostaju u vešu i dolaze u direktan kontakt sa kožom.
Ako imate osetljivu kožu, ili patite od ekcema, ovaj problem se drastično pogoršava.
Razvoj gljivica i bakterija
Znoj i vlaga koji se zadržavaju u vlaknima predstavljaju savršeno stanište za gljivice i bakterije. Veš koji ne diše stvara tamno, vlažno i toplo okruženje – idealno za razmnožavanje patogena.
Posledice su višestruke:
- Gljivične infekcije: Donji veš i čarape napravljeni od neprozračnih materijala mogu dovesti do gljivičnih infekcija prepona ili atletskog stopala.
- Akne na telu: Sintetička sportska odeća koja zadržava znoj često je glavni uzrok akni na leđima i grudima (tzv. body acne).
Hronični neprijatan miris
Još jedan znak da veš „ne diše“ je uporan, hroničan miris. Čak i nakon pranja, odeća može brzo da poprimi neprijatan, ustajao miris.
Zašto veš smrdi nakon pranja? Zato što bakterije koje uzrokuju miris i masnoća ostaju zarobljene unutar vlakana, a omekšivač, umesto da pomogne, stvara premaz koji ih dodatno „pečatira“ iznutra.
Zašto veš „gubi dah“? Tri ključna uzroka

Da biste rešili problem, morate razumeti uzroke.
Pogrešan izbor materijala
Sposobnost veša da „diše“ direktno zavisi od vlakna.
- Sintetika (Poliester, Najlon): Ova vlakna su u suštini plastika. Iako brzo odvode vlagu sa površine kože, oni je zadržavaju unutar svojih vlakana, što dovodi do brzog razvoja neprijatnih mirisa i zagušenja.
- Prirodni materijali (Pamuk, Lan, Vuna i Bambus): Prirodna vlakna su prozračnija i omogućavaju da se vlaga prirodno oslobađa, smanjujući rizik od zadržavanja bakterija. Posebno treba istaći veš od bambusa. Bambusova vlakna su izuzetno mekana, prirodno antibakterijska i imaju superiornu moć upijanja i odvođenja vlage, čime osiguravaju da vaša koža diše mnogo bolje od većine drugih materijala.
Prekomerna upotreba hemikalija
Najveći neprijatelj prozračnosti veša je omekšivač. Iako obećava mekanost i dugotrajan miris, on funkcioniše tako što oblaže svako vlakno masnim, voštanim filmom.
Taj film, iako čini veš mekanim, istovremeno:
- Zagušuje vlakna, čineći ih nepropusnim za vazduh.
- Smanjuje sposobnost odeće da upija vodu (posebno kod peškira i sportske odeće).
- Zarobljava bakterije i masnoću iznutra, što dovodi do hroničnog smrada.
Loš program i temperatura pranja

Pranje veša na preniskoj temperaturi ili korišćenje kratkih programa sa nedovoljnim ispiranjem, često ostavlja za sobom tragove deterdženta.
Ako se ta hemija ne ispere, ona se taloži i doprinosi zagušenju vlakana.
Vodič za prozračnost materijala
Ovo je brz vodič koji će vam pomoći da donesete pametnije odluke pri kupovini i pranju:
| Materijal | Tip „Disanja“ | Potencijalni Zdravstveni Rizik | Preporuka za Pranje |
|---|---|---|---|
| Pamuk | Visoka | Niska (ako se dobro suši) | Toplije pranje, izbegavati višak omekšivača. |
| Lan | Najviša | Niska | Prirodni materijali, brzo se suše, nežna sredstva. |
| Poliester | Niska (zadržava znoj) | Visoka (bakterije, mirisi) | Koristiti minimalno deterdženta, izbegavati omekšivač. |
| Akril/Najlon | Niska | Srednja (irirtacija) | Oprez, brzo se zagušuje masnoćom i mirisom. |
| Vuna | Srednja/Visoka | Niska (prirodno antibakterijska) | Specijalno pranje/program za vunu, nežni deterdženti. |
Rešenja: kako osvežiti veš i kožu
Srećom, problem zagušenog veša je rešiv.
Ključ je u prelasku na prirodnija i manje agresivna rešenja za negu odeće.
Trikovi za detoksikaciju veša

Ako imate veš koji je već „zapečaćen“ omekšivačem i smrdi, možete ga „detoksikovati“:
- Sirće i Soda: Za temeljno čišćenje i uklanjanje naslaga. Dodajte pola šolje belog alkoholnog sirćeta u pregradu za omekšivač tokom ciklusa pranja. Sirće deluje kao prirodni de-gummer (uklanjač naslaga) i dezodorans.
- Dubinsko čišćenje mašine: Ne zaboravite da mašina koja smrdi zagađuje vaš veš. Pokrenite prazan ciklus sa šoljom sirćeta na najvišoj temperaturi jednom mesečno.
Pametan odabir sredstava za pranje

Najvažnija promena koju možete da napravite za zdravlje vaše kože i dugovečnost odeće je – izbacite klasični omekšivač.
Umesto agresivnih hemikalija i omekšivača, koristite prirodne alternative:
- Ekološki deterdženti: Koristite minimalne količine.
- Prirodni mirisi: Koristite prirodne arome i mirise kako bi vaš veš predivno mirisao, ali bez zagušujućeg hemijskog sloja.
Za kraj
Zdravlje vaše kože i osećaj svežine direktno su povezani sa stanjem vašeg veša. Ako vaša odeća „ne diše“, to znači da se u vlaknima nakupljaju hemikalije, masnoće i bakterije koje iritiraju kožu i ugrožavaju higijenu.
Rešenje nije u dodavanju više hemikalija i mirisa, već u njihovom izbegavanju. Oslobodite svoju odeću od zagušujućeg filma i pređite na prirodna rešenja za pranje i negu. Učinite uslugu i vašoj koži i vašoj mašini za veš – one će vam biti zahvalne.
